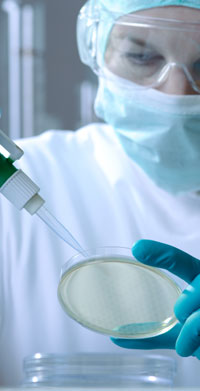

about us
Connecting markets with innovative medical technologies and API manufacturers with formulation factories, both at home and abroad is the core business of Hakimsons (Pvt.) Ltd. Founded in 1948 we enjoy over fifty years of strategic partnerships with leading pharmaceutical and medical companies. With a diverse product portfolio we have established ourselves as leading suppliers of Active Pharmaceutical Ingredients and Medical Disposable and Devices in Pakistan. From addressing logistical needs to assisting acquisition of technologically advanced solutions our services have been customized to identify and meet the individual needs of our valuable patrons.
marketing activities
- Medical Diagnostics
- Medical Equipment
- Medical Disposables
- Pharma Raw Material & Intermediates
- Packaging Material
- Industrial Chemicals
- Petro Chemicals
- Rubber Chemicals
- Food Additives
Medical Products
With a highly intricate distribution network and an equally sophisticated brand management setup, we enjoy outstanding patronage from both medical professionals and Institutions. Our length of association, which in some cases is more than two decades long with medical companies, such as CR Bard of USA, Flexicare Medical Ltd of UK and Nessler Medizintechnik of Austria, is indicative of our commitment to serving our principals' objectives and achieving brand success. Determined to further diversify our range of medical solutions, we seek global alliances with companies offering innovative new technologies.
- Urology Products
- Cardiac Surgery Products
- Oncology Products
- Respiratory Care Equipment
- General Surgery Products
- Interventional Radiology Products
- Vascular Access Products
- Anesthesia & Respiratory Care Products
- Disposable E.C.G. Electrodes & Accessories
- Electro-Surgical Units

Fine Chemicals
Now in it's sixth decade of operation our Fine Chemicals division is a leading vendor to the local pharmaceutical, food and chemical industry with some very old and time tested global partnerships to its credit. With the advent of the new millennium we have evolved from an indenting company to a marketing firm, replacing selling with a combination of brand management and personalized customer services. Responding to the dynamic nature of the industry's needs, we wish to further extend our portfolio of products by exploring new opportunities of business co-operation. Expansion to markets abroad will further add to our existing clientele and fortify our business with a dimension of global presence.
Pharma Raw Material
- Ant-Acids/Anti-Ulcer ants
- Antibacterial
- Antibiotics
- Anti-Tuberculosis
- Anti-Inflammatory Agents
- Corticosteroids
- Neurotropic Agents
- Bulk Vitamins
- Xanthene Derivatives
- Fine Chemicals & Intermediates
Chemicals & Commodities
- Industrial Chemicals
- Petro - Chemicals
- Agro - Chemicals
- Fero Alloys
- Non - Ferrous Metals
- Edible Oils
- Inedible Tallows
- Plastics Compounds & Polymers
Global Alliance
Medical Equipment Division
 Bard International Inc. USA
Bard International Inc. USA
Vascular, Urology, Oncology, and Surgical Specialty Equipment
 Megadyne Medical inc, USA
Megadyne Medical inc, USA
Ace Cutting System, Electrodes, Bipolars, Suction Coagulators, Laparoscopics, loops.
 FLexicare Medical, UK
FLexicare Medical, UK
Airway Management, Anesthesia Breathing System, Anesthesia Components, Critical Care, Neonatal Breathing Systems, Breathing Filters, Oxygen & Aerosol therapy, Resuscitation, Suction, Urology & Continence Care, Ostomy Care, Enema Tips
 Pennine Healthcare, UK
Pennine Healthcare, UK
Airway Management, Custom Procedure Packs, Gastroenterology, Micro suction, Respiratory, Surgical Suction, Urology, Specialist Medical Devices
 Biometrix Medical, Netherlands
Biometrix Medical, Netherlands
Critical Care, Angio-graphy and Cath-lab, Surgery, Biometrix CPT Products.
 Bio-protech inc, korea
Bio-protech inc, korea
ECG Electrodes, Neurology, ESU Plates, ESU Pencil, TENS Electrodes, SpO2 Sensors, TENS Units, EMS Units, IF Units
 nessler medizin technikm, Austria
nessler medizin technikm, Austria
ECG Electrodes, Neutral Electrodes, Conductine Electrodes & Consumables.
 hospitech, malaysia
hospitech, malaysia
Blood & IV care, Blood Bag Systems, Disposable Procedures, Gauze & Bandages, Gynaecology, PVC Tubing & Catheter, Renal Care, Respiratory care, Thoracic & Critical care, Urology
Bulk Raw Materials

Arthur Branwell, UK- : Gums

Takeda Chemical Industries, Japan : Food- Tsuno Rice, Japan : Inositol
- Fuji Kasei, Japan : Anti-Fungal
- Kirin Foods, Japan : Flavor Enhancers

Henan Lihua, China : Hormones- Ningbo Smart, China : Bulk Analgesics
- NEGPF, China : Bulk Anti-Infectives
- Shenyang Antibiotics, China : Bulk Anti-Infectives
- Shanghai Sunve, China : Bulk Drugs
- Yanchang Suhai, China : Bulk Drugs
- Hubei Xianning Pharmaceuticals, China : Vitamins
- Chemvon Biotechnology, China : Ophthalmic
- Chongqing Holley Group, China : Anti-Malarial
- Desano Group, China : Vitamins
- Huasha Pharma, China : Antibiotics
- Jiangsu Swellxin, China : Anti-Malarial
- Jiangxi Synergy, China : Anti-Infective
- Liaoning Jiayi, China : Minerals
- Nutrex, China : Nutrition
- Pharmedical, China : Analgesics
- Shanghai New Hualian, China : Steroids
- Sinochem Qingdao, China : Spasmodic
- Suzhou Tianma, China : Anti-hypertensive
- Wuhan Amino Acids, China : Amino Acids
- Zhejiang Jianfeng, China : Anti-Jussive
- Zhejiang Jingxin, China : Quinolones

Global Calcium, India : Calcium Salts- Lupin, India : Anti-Infectives
- Inga Pharma, India : Alkaloids
- Kopalle Pharma, India : Ophthalmic
- Nosch Labs, India : Antiulcer
- Reine Chemicals, India : Anti-anemia
- Taurus Chemicals, India : Antacids

General Minerals, U.A.E. : Calcium Salts
Contact Us
For Enquiries related to Medical Equipment Division:
Contact Person:
Mumtaz Zafar
Unit Head Medical Division
mumtaz.zafar@hakimsonsgroup.com
Cell No. +92-300.8234820
For Enquiries related to Fine Chemical Division:
Contact Person (Karachi Office):
Iqbal Qureshi
Executive Manager
Iqbal.qureshi@hakimsonsgroup.com
(Cell No. +92-300.8287215)
Anis Mohsin (Karachi Office):
Manager Business Development
anis.mohsin@hakimsonsgroup.com
(Cell No. +92-300-8287214)
Azhar Khaliq (Lahore Office)
Manager Indent
azhar.khaliq@hakimsonsgroup.com
(Cell No. +92.333.4323504)
For General Enquiries:
Hakimsons Private Limited.
Hakimsons House, A/56, S.I.T.E, Manghopir Road,
Karachi-75700, Pakistan
Tel: +92 (21) 32570182-83
Fax: +92 (21) 32564393
Email: hpl@hakimsonsgroup.com